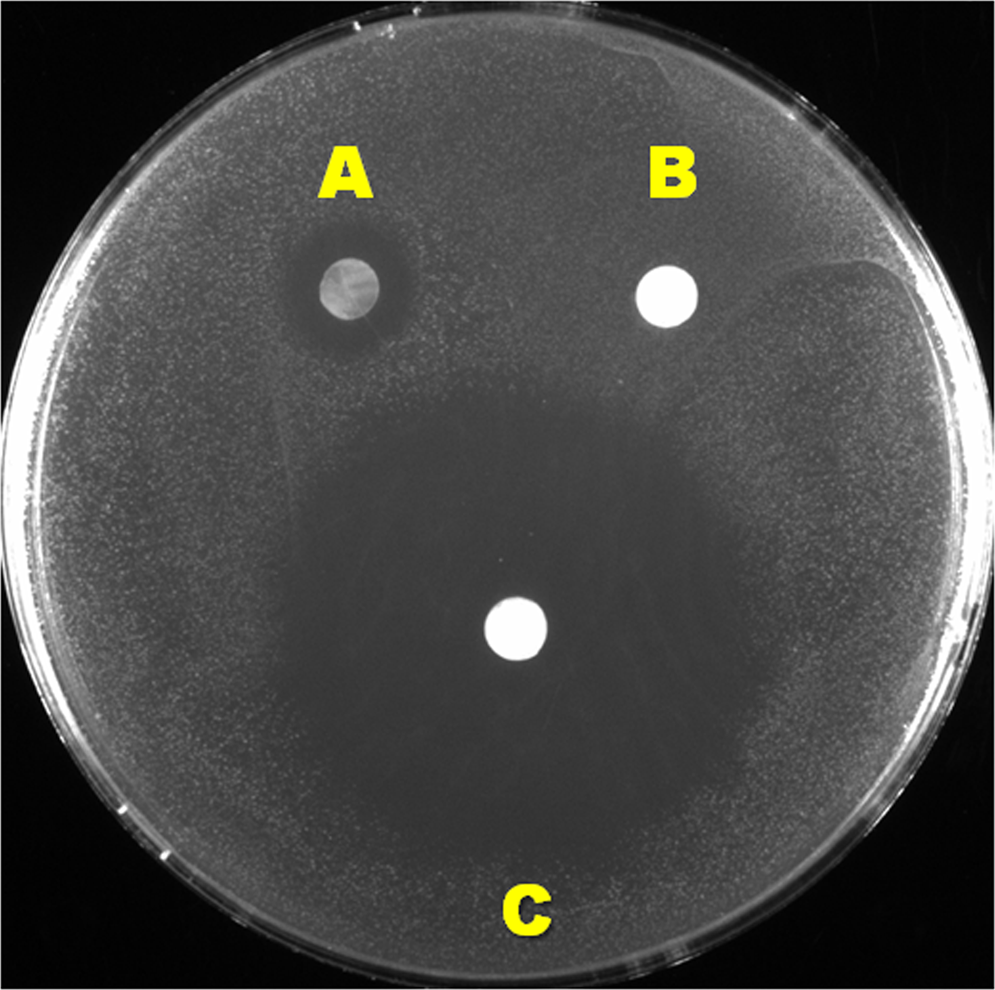
Figure 6

Figure 6
From: Antimicrobial Efficacy Assessment of Human Derived Composite Amnion-Chorion Membrane
Disc diffusion assay. Log phase S. gordonii cells were plated on THB agar, and incubated with ACM (A), PPCM (B), and tetracycline-soaked PPCM (C) for 24 hours. The clear zone of bacterial absence around ACM was substantially smaller in diameter than that of the antibiotic disc on the agar.
